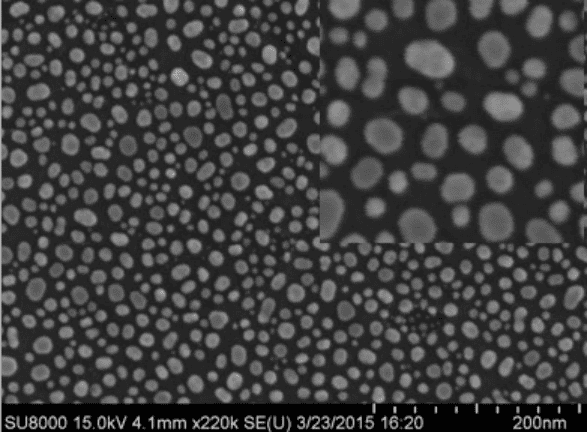
圖片關(guān)鍵詞 圖片關(guān)鍵詞

- 返回 |
- 網(wǎng)站首頁
- / 項(xiàng)目案例
- / 安裝案例
- / 安裝于13樓的SEM順利通過驗(yàn)收-AVI 主動(dòng)式防震臺(tái)為電鏡保駕護(hù)航
2015年3月23日,我司工程師在南京大學(xué)科技樓13樓實(shí)驗(yàn)室進(jìn)行了AVI主動(dòng)式減震臺(tái)與日立SU8010 場(chǎng)發(fā)射電鏡的聯(lián)機(jī)安裝,經(jīng)過工程師的精心的安裝與調(diào)試,開啟主動(dòng)式減震之后的掃描電鏡,在拍圖的效果上呈幾何倍數(shù)的提高,且分辨率達(dá)到1個(gè)納米的數(shù)量級(jí),得到了實(shí)驗(yàn)室老師的一致贊同并給予主動(dòng)式減震臺(tái)當(dāng)場(chǎng)驗(yàn)收的待遇,此次安裝圓滿結(jié)束。
安裝完成后的整體效果圖:

如圖所示,AVI防震臺(tái)安裝于日立SU8010 SEM底部,整體性一致
開啟和關(guān)閉防震臺(tái)的電鏡照片比較
為驗(yàn)證防震效果,開啟和關(guān)閉防震臺(tái),進(jìn)行觀察照相,獲得的電鏡照片如下:
關(guān)閉防震臺(tái)拍照效果

開啟防震臺(tái)拍照效果
從上述照片可以看出,防震臺(tái)處于關(guān)閉狀態(tài)電鏡拍攝的照片基本無法使用,而使用防震臺(tái)后,電鏡得到的照片的震動(dòng)條紋大為減輕、清晰度明顯變好,拍攝1個(gè)納米的樣品細(xì)節(jié)清晰度效果好。
防震臺(tái)的使用概況:
普通掃描電子顯微鏡(SEM)當(dāng)安置到樓房高層(2層以上),或置于有強(qiáng)震動(dòng)的場(chǎng)地時(shí)(例如附近地下有地鐵,),高倍率3萬倍以上觀察、照相就無法進(jìn)行。而使用震動(dòng)隔離系統(tǒng)-防振臺(tái)。場(chǎng)發(fā)射電鏡(FEM)要在幾十萬倍觀察和照相,對(duì)震動(dòng)要求更高。即便安裝在一樓,也都不能滿足要求。一般都要求安裝防振臺(tái)。
優(yōu)尼康科技有限公司代理瑞士Table Stable多款主動(dòng)式防震臺(tái)。其AVI產(chǎn)品為2個(gè)或以上的分離單元隔振墊塊,安裝非常方便。
